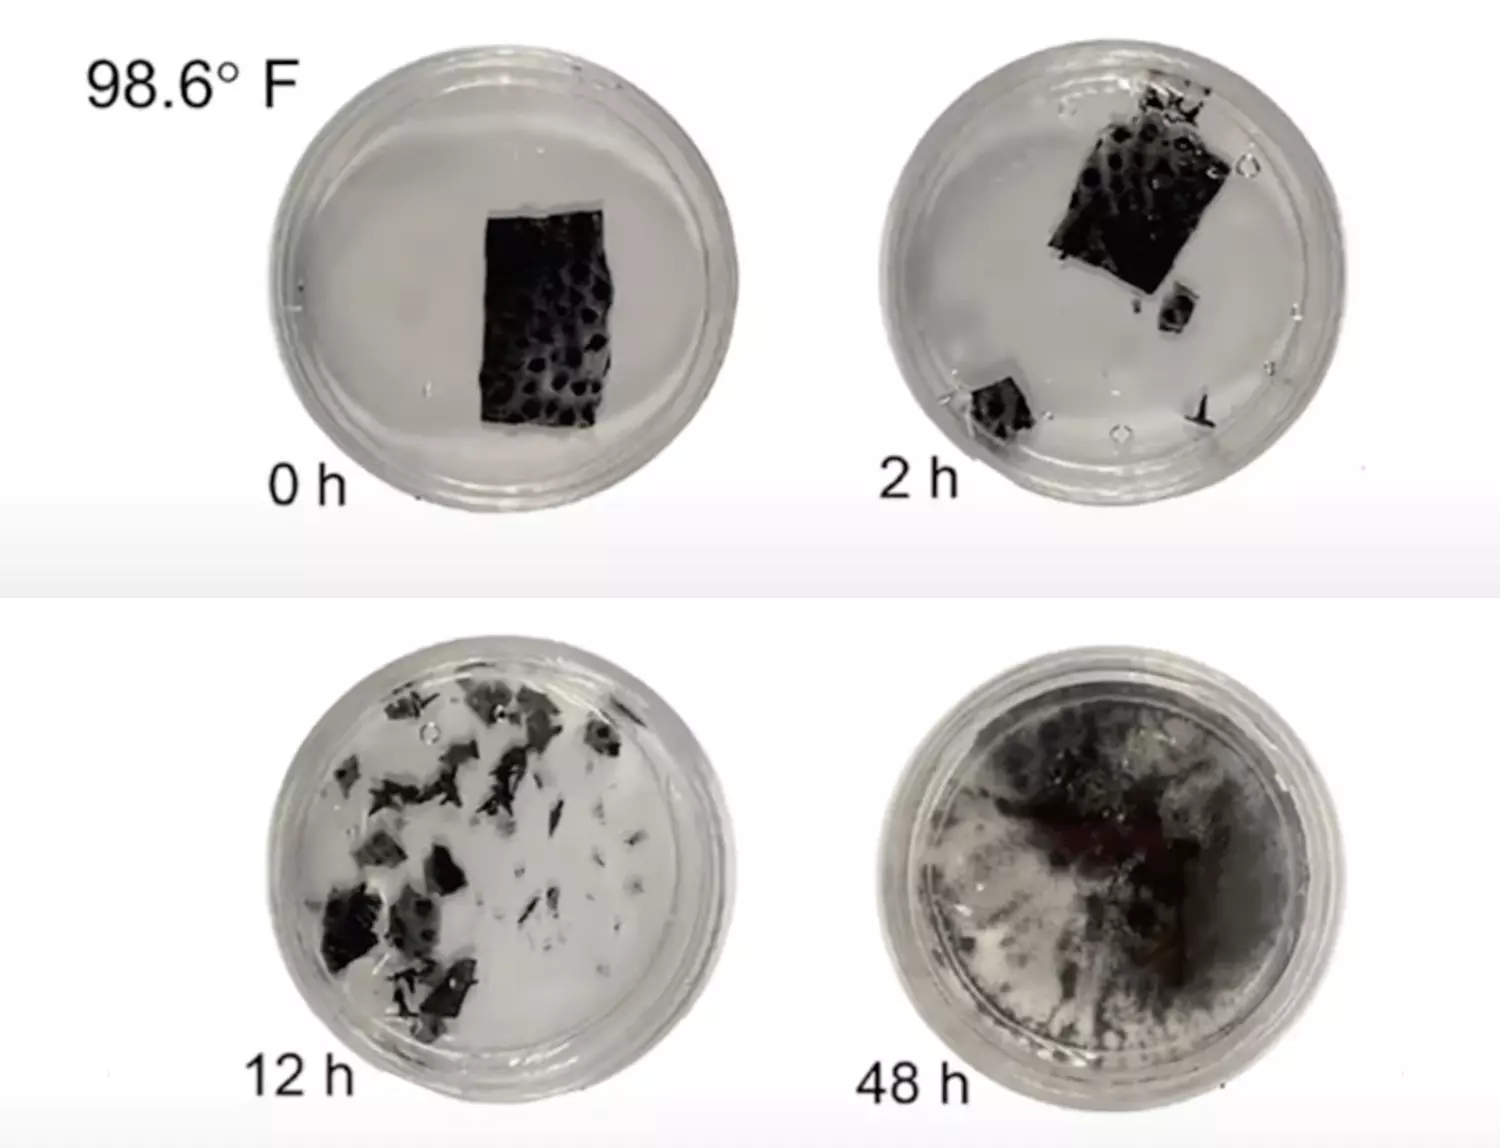
3 необычных робота, которые понравились читателям Хабра - 4

Решили вспомнить про самые интересные проекты из наших подборок про магнитных, насекомоподобных и модульных роботов. С этой задачей нам помогли читатели: в конце каждой статьи они голосовали за лучших и делились своим мнением в комментариях. Нам выбор хабравчан понравился, поэтому решили собрать еще один текст.
В конце статьи — конкурс на плюшевого тирекса и другой мерч Selectel.
Модульный робот M-Blocks
Одним из первопроходцев в мире модульной робототехники стал молодой инженер Джон Романишин. В 2013 году он создал схему самосборки роботов. Небольшие кубики без внешних подвижных частей могут передвигаться, прыгать и соединяться друг с другом. Технология получила название M-Blocks.

M-Blocks, без корпуса. Источник
Магии здесь нет: внутри каждого кубика установлен маховик, вращающийся со скоростью 20 000 оборотов в минуту. В момент резкой остановки «создается» инерция, которая побуждает куб двигаться в определенном направлении.
Чтобы кубы стыковались между собой, на ребрах каждого из них есть цилиндрические магниты. Когда два блока сближаются, магниты поворачиваются друг к другу разноименными полюсами и «слипаются» в месте стыка.
В первой версии кубы передвигались почти хаотично, с помощью динамики и магнитного воздействия. Через шесть лет вышел второй, более «осознанный» вариант M-Blocks: кубики научились различать друг друга с помощью специальных датчиков. О том, как это работает, рассказали в прошлой статье.
Робот-насекомое RoboBee
В 2013 году ученые из Гарварда разработали робота-насекомого для работы в воздушной среде — робота-пчелу RoboBee. У проекта есть несколько версий.
Первая версия. Сначала робот умел только летать, притом его конструкция несильно напоминала пчелу. Внешне он, кажется, больше похож на стрекозу. Его габариты соответствующие: длина — 3 см, масса — 80 мг.
Миниатюрности инженеры достигли благодаря хитрым пьезоэлектрическим моторчикам и легкому материалу из углеродистого волокна.
Даже звук полета RoboBee напоминает шелест крыльев стрекозы. Хотя их частота меньше, чем у робота: 80 Гц против 120 Гц.
Первая модель RoboBee не работала автономно: требовалось подключение к внешнему источнику питания через протянутый провод. Оттого полеты робота напоминают игру с воздушным змеем.
Вторая версия. Через два года разработчики доработали проект и заявили, что робот может перемещаться под водой. Но не все так однозначно: вторая версия RoboBee способна лишь на переход из воздушной среды в воду.
RoboBee переходит из воздуха в воду.
При погружении в воду частота взмахов падает настолько, что робот уже не может подняться обратно. Ученые нашли решение проблемы и сконструировали третью версию RoboBee — о ней мы рассказали в прошлой статье.
Магнитный робот из гидрогеля
Последняя разработка в подборке — полная противоположность прошлых проектов. На борту мягкого магнитного робота отсутствуют электронные компоненты, в его основе — ферромагнитный гидрогель Hof-Gel15-Fe3O4 из желатина и частиц оксида железа.
Благодаря своему химическому составу робот можно использовать для доставки лекарств в отдельные участки организма: его не нужно извлекать из организма хирургическим путем. Мягкий магнитный робот растворяется за 48 часов при температуре человеческого тела.
Робот растворяется в воде. Источник
Робота не зря называют мягким: он умеет изгибаться, сворачиваться и перемещаться, как гусеница. Для этого у него есть маленькие лапки: они нужны для захвата крошечных объектов.
Перемещая и поворачивая магнит можно управлять роботом — заставлять его сгибаться и двигаться кувырками.
Робот перемещается кувырками.
Можно ли повторить этого робота в домашних условиях? На этот и другие вопросы ищите ответы в подборке магнитных роботов.
Поделитесь, каких роботов не хватает в вашей профессиональной деятельности. Может, вы давно мечтаете о наставнике вроде K9 из Доктора Кто? Не бойтесь фантазировать: за самые развернутые и интересные идеи отправим плюшевых тирексов и другой мерч Selectel. Итоги подведем через две недели.
Автор: Влад Ефименко

